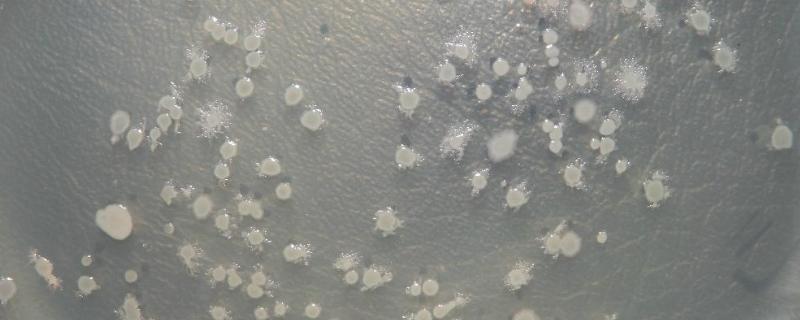
什么情况下使用芽孢菌调水，芽孢菌多少度能杀死

蓝莓葡萄是什么品种

蓝莓葡萄是指摩尔多瓦葡萄,是摩尔多瓦的稀有葡萄品种,其果皮颜色跟蓝莓类似,呈蓝黑色,所以被称为蓝莓葡萄。蓝莓葡萄为中晚熟品种,果穗圆锥形,平均穗重为650g,果粒着生较为紧密,呈短椭圆形,平均粒重9g左右,纵径约2.58cm,横径约2.2cm,着色整齐,果粉较厚,果肉柔软多汁,可食用率几乎能达到100%。
一、蓝莓葡萄果实特征
1、蓝莓葡萄(摩尔多瓦葡萄)为中晚熟品种,果穗呈圆锥形,中等大小,着生中等紧密,平均穗重为650g。
2、蓝莓葡萄果粒较大,呈短椭圆形,平均粒重为9g左右,最大可达13.5g,纵径约为2.58cm,横径约为2.2cm。果皮为蓝黑色,果粉较厚,着色整齐一致。

3、蓝莓葡萄的果肉柔软多汁,口感一般,可溶性固形物含量为16-18.9%(最高可达20%),含酸量0.54%。
4、蓝莓葡萄的果肉与种子容易分离,每颗葡萄中含有1-3粒种子。

二、蓝莓葡萄树体特征及生长特征
1、蓝莓葡萄嫩梢为绿色至黑绿色,幼叶为绿色,边缘处有暗红晕,叶背和叶面具有稠密的绒毛。成龄叶片同样为绿色,呈近圆形,叶缘上卷,三裂或全缘,裂刻较浅,叶片表面无毛,叶背绒毛稀疏。
2、叶柄为紫红色,长约9-10cm,叶柄洼闭合成椭圆形。幼茎有暗红色纵条纹,密被绒毛,一年生成熟枝条为深褐色,节间长。冬芽大而饱满,有紫红色的晕斑。

3、如果是在重庆地区种植的话,3月初便会开始萌芽,5月初开始开花,7月果实开始着色,8月下旬果实会完全成熟。而枝条在7月上旬开始老熟,11月下旬开始落叶。
4、蓝莓葡萄结实力极强,平均每个结果枝有1.65个果穗,适合在庭院、盆栽、长廊、公园等地方栽种。同时还高抗霜霉病,中抗白粉病和黑痘病。

5、蓝莓葡萄结实时间早,丰产性强,当行株距为2.4×1m时,移栽第二年的亩产量为800kg左右,第三年的亩产量为2100kg左右。
- 问蓝莓结果期施什么肥蓝莓进入结果期之后一般可以施低浓度的磷酸二氢钾溶液等肥料。注意事项:不能施用浓度过高的化肥,否则有可能会导致植株出现落果的现象;肥料的使用频率不宜太高,一般每个月施用1次即可,因为施肥过于频繁容易出现肥害。
- 问蓝莓品种大全常见的蓝莓有美登、蓝丰、陶柔、达柔、芬蒂、北村、北蓝、北陆、爱国者、埃利奥特、康维尔、芭尔德温等品种。美登:中熟品种,果实呈深蓝色,形状为圆形,果粉较厚,成熟后具有清香味。蓝丰:中熟品种,植株长势健壮,连续丰产能力强,果实较大,果粉较厚,肉质较硬,具有清淡的芳香味。陶柔:早熟品种,果实较大,颜色深蓝,香味较浓。
- 问蓝莓适合盆栽还是地栽,附种植方法和注意事项1、栽培方式选择:蓝莓盆栽和地栽均可,如果是盆景观赏,以盆栽为宜,如果是销售新鲜蓝莓浆果,以地栽为宜。2、盆栽和地栽的区别:盆栽蓝莓产量远不及地栽蓝莓,因为蓝莓根系为吸收无机盐和水分的器官,而盆栽蓝莓的根系生长发育远不及地栽蓝莓,并且盆栽蓝莓不好控制中量和微量元素肥料的施加量,容易出现施肥过度或施肥不足。
- 问双流蓝莓基地在哪里双流(成都市双流区)的蓝莓基地在太平镇桃源村、金桥镇等地方。蓝莓又名笃斯、黑豆树、都柿、甸果、地果、龙果、蛤塘果,它是一种属于杜鹃花目、杜鹃花科、越橘属的植物,由于其果实中含有丰富的营养成分(尤其是富含花青素),因此成为了世界粮农组织以及农业组织推荐食用的五大健康水果之一。
三农问答